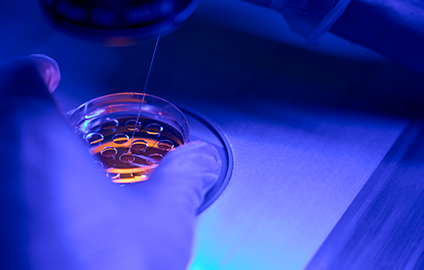
imagem

(49) 99840-0608
-
-
-
Estrada São Roque - Treze Tílias, SC
Estrada São Roque - Treze Tílias, SC
● Coleta e Transporte do embrião;
● Sincronização doadora/receptora;
● Transferência de embrião;
● Tratamentos de infecções uterinas.